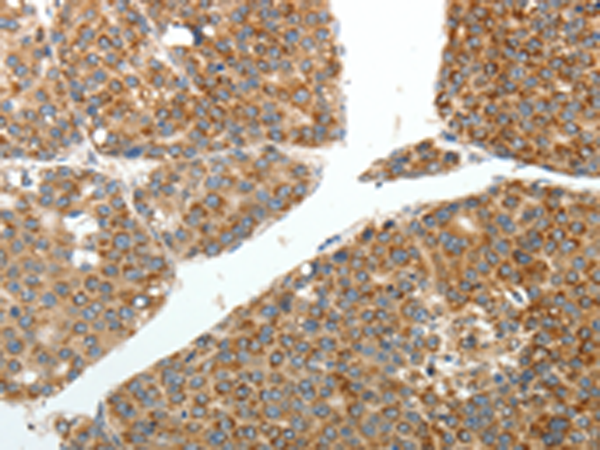

中文名稱:兔抗RETNLB多克隆抗體
英文名稱: Anti-RETNLB rabbit polyclonal antibody
別 名: XCP2; FIZZ1; FIZZ2; HXCP2; RELMb; RELMbeta; RELM-beta
儲 存: 冷凍(-20℃)
宿 主: Rabbit
相關(guān)類別: 一抗
反應(yīng)種屬: Human
標(biāo)記物: Unconjugate
克隆類型: rabbit polyclonal
技術(shù)規(guī)格
|
IHC Recommend dilution: |
25-100 |
|
IHC positive control: |
Human liver cancer and Human ovarian cancer |
|
ELISA Recommended dilution: |
2000-5000 |
|
SwissProt: |
Q9BQ08 |
|
Synonyms: |
XCP2; FIZZ1; FIZZ2; HXCP2; RELMb; RELMbeta; RELM-beta |
|
Full name: |
resistin like beta |
|
Immunogen: |
Fusion protein of human RETNLB |
|
Name of antibody: |
RETNLB |
|
Applications: |
ELISA, IHC |
|
Background: |
Resistin-like beta is a protein that in humans is encoded by the RETNLB gene. An infusion of either resistin or RELMB in rats rapidly induced severe hepatic but not peripheral insulin resistance. Increases in circulating resistin or RELMB levels markedly stimulated hepatic glucose production despite the presence of fixed physiologic insulin levels. This enhanced rate of glucose output was due to increased flux through glucose-6-phosphatase. The results supported the notion that a novel family of fat- and gut-derived circulating proteins modulates hepatic insulin action. |
購物車
幫助
021-54845833/15800441009
